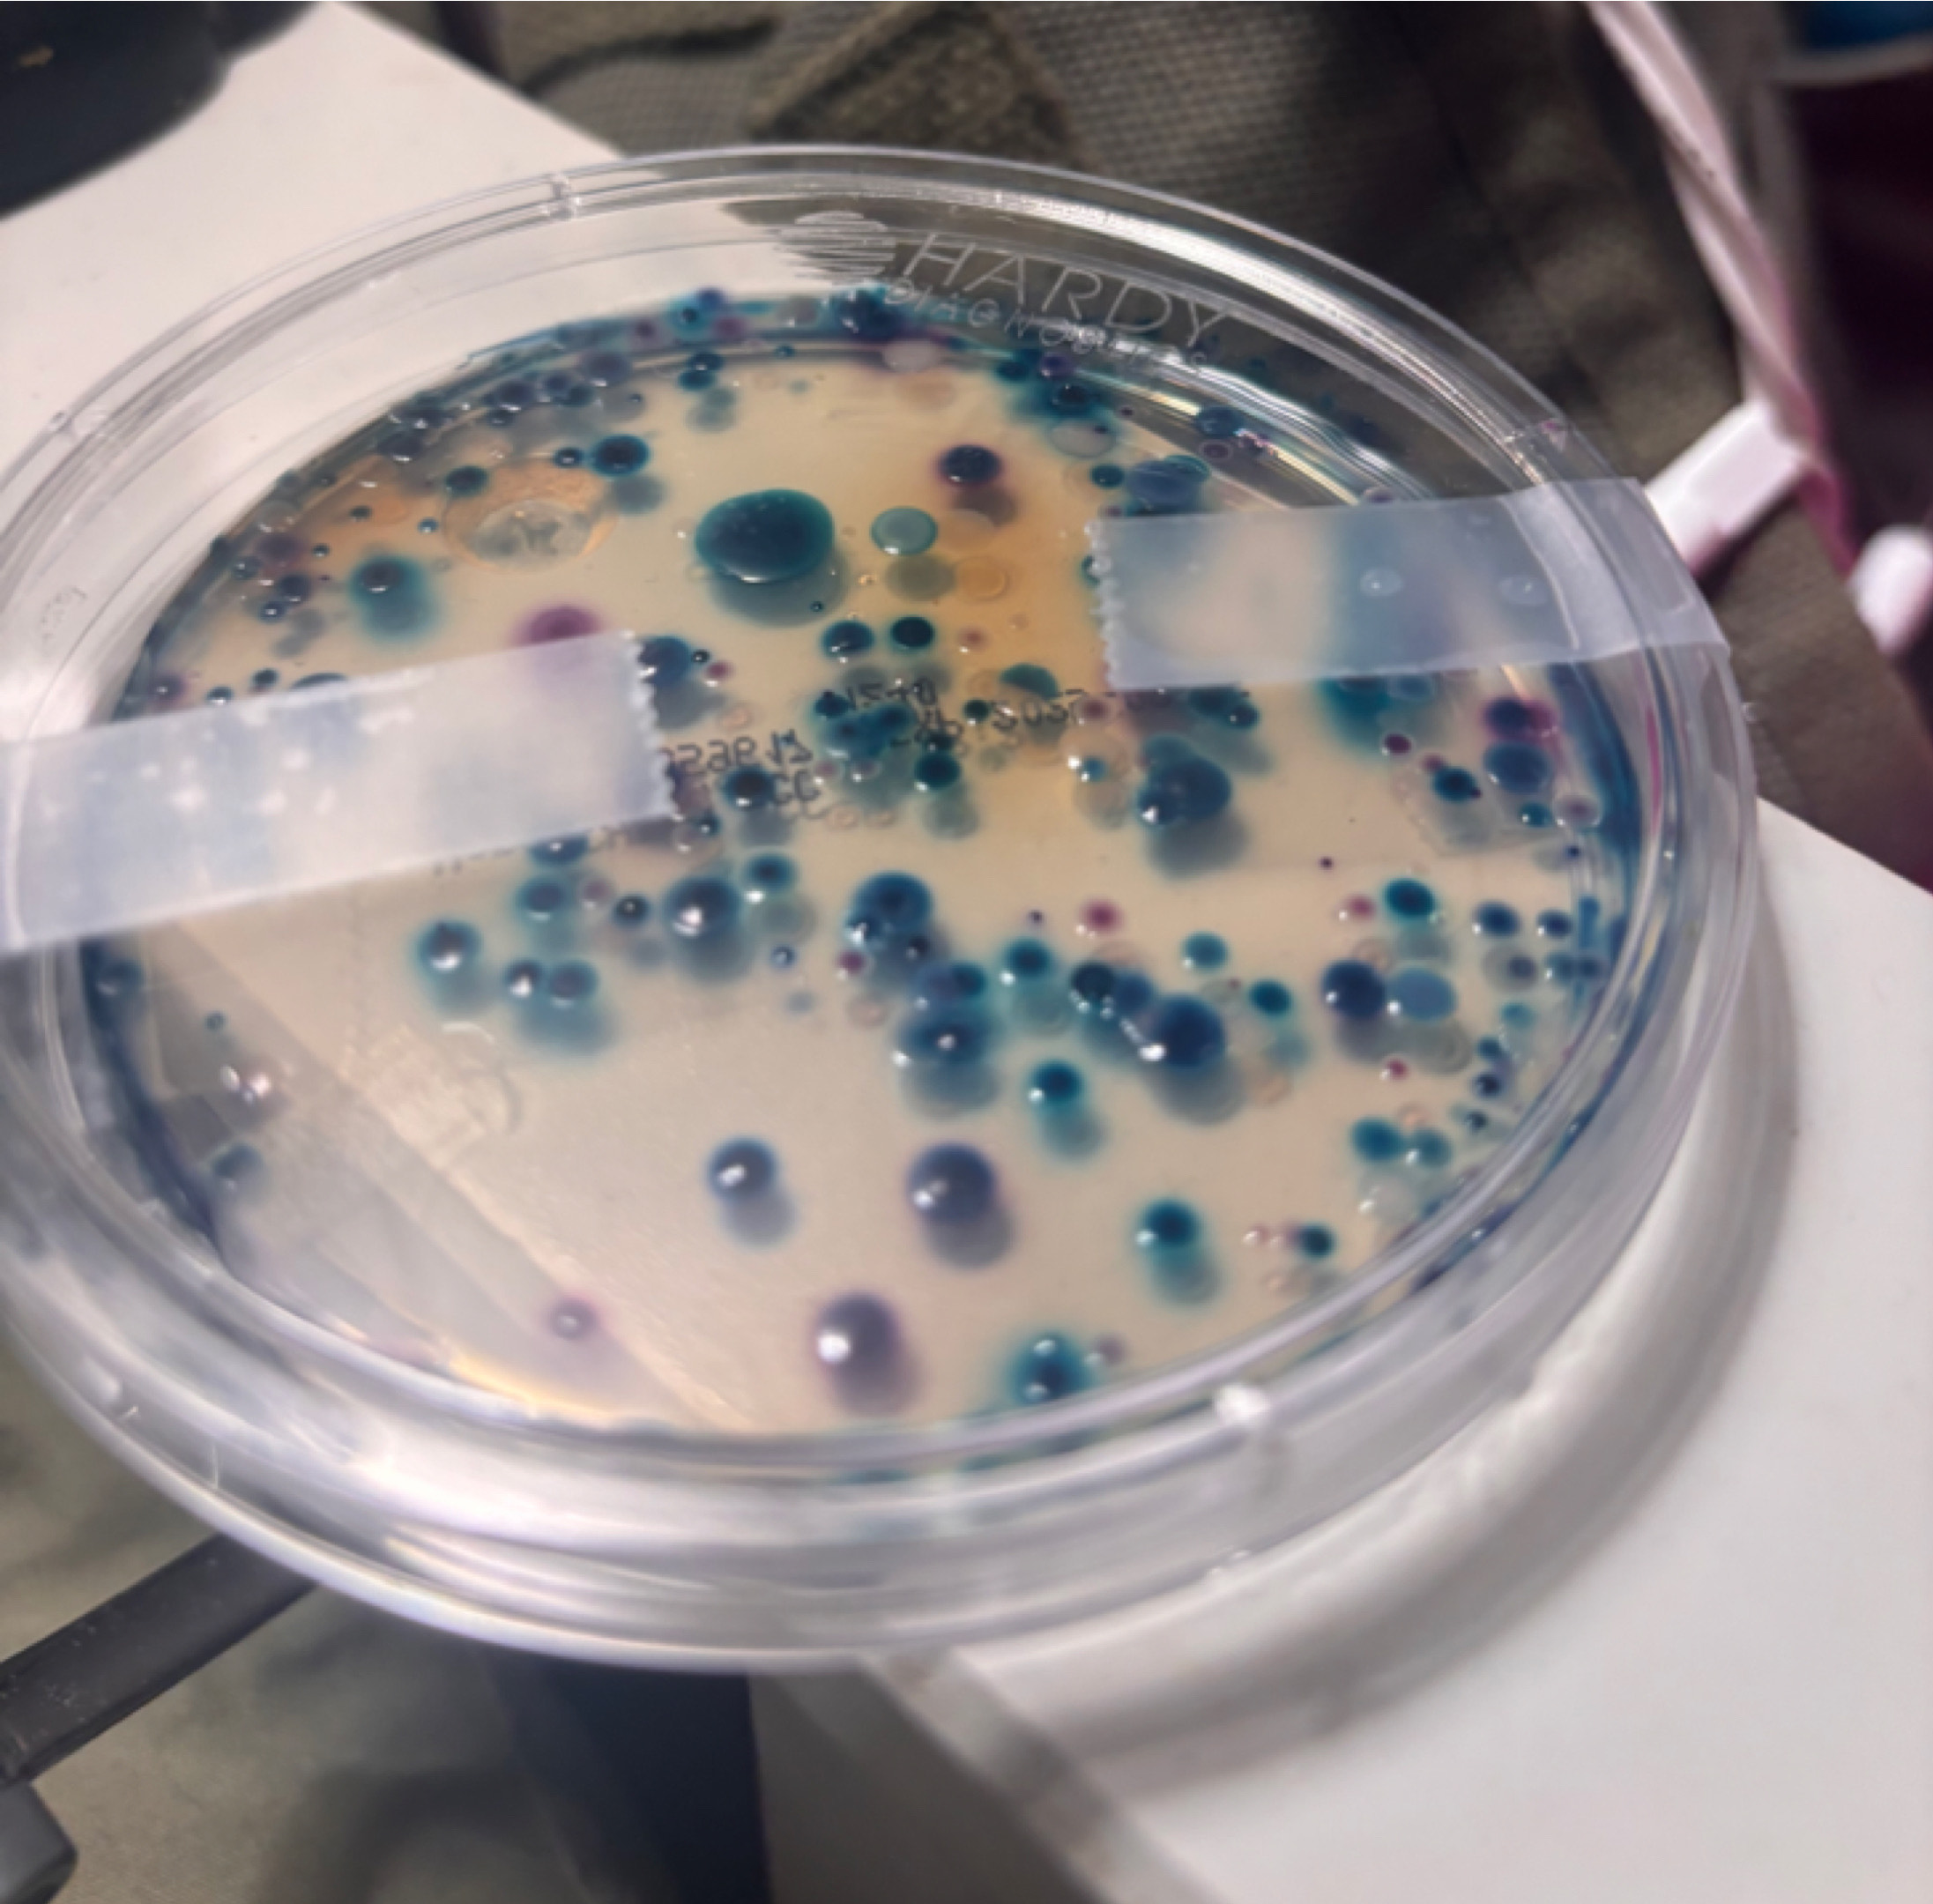

Our Why
SCCW aims to support students at Northwest School of the Arts by creating hands on STEM experiences. This project gives our students opportunities that prepare them to transition into higher-level education.



Our How
By providing our students with professional training, we were able to send our students all over North Carolina to test this summer. These tests include pH, dissolved oxygen, fecal coliform, temperature, and turbidity. All the data and the database are result of hard work from our students.